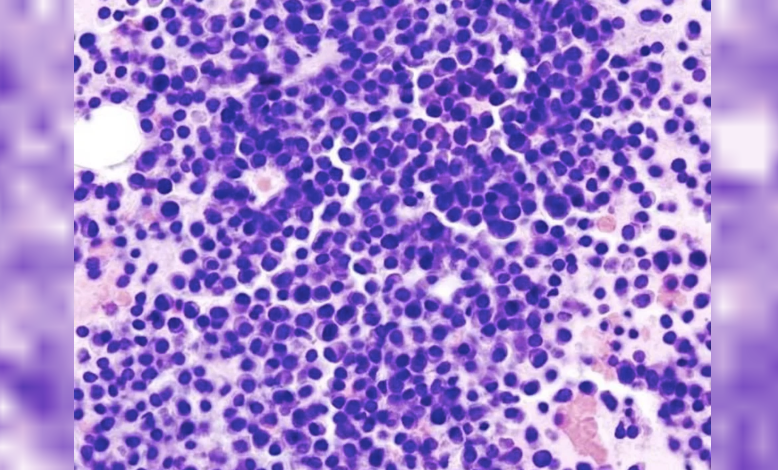

Es para pacientes recientemente diagnosticados que no son candidatos a trasplante de células madre.
pacientes
El mieloma múltiple es un tipo de cáncer hematológico poco frecuente, que se origina en las células plasmáticas de la médula ósea, las cuales se multiplican descontroladamente, producen anticuerpos defectuosos y afectan la producción normal de glóbulos rojos, blancos y plaquetas, generando potencialmente complicaciones graves como insuficiencia renal, anemia, fracturas óseas, hipercalcemia e infecciones recurrentes.
En la Argentina, proyecciones de incidencia de mieloma múltiple permiten estimar la existencia de alrededor de 1.300 nuevos casos por año, lo que equivale en promedio a 3,5 diagnósticos cada día. La prevalencia aumenta con la edad, con un pico entre los 50 y los 70 años.
Ahora, la Administración Nacional de Medicamentos, Alimentos y Tecnología Médica (ANMAT) aprobó una nueva indicación del anticuerpo monoclonal daratumumab para pacientes con mieloma múltiple en los que no se haya previsto un trasplante autólogo de células madre como terapia inicial o que no son elegibles para un trasplante autólogo de células madre.
La nueva indicación aprobada por ANMAT se basa en los resultados del estudio clínico internacional de fase 3 CEPHEUS, que evaluó la eficacia y seguridad de agregar daratumumab al tratamiento estándar de quimioterapia (una combinación de bortezomib, lenalidomida y dexametasona, conocido como VRd) en los que no se haya previsto un trasplante autólogo de células madre como terapia inicial o que no son elegibles para un trasplante autólogo de células madre.
En el estudio CEPHEUS participaron más de 700 pacientes. Los resultados fueron contundentes: 6 de cada 10 (60,9%) de los que recibieron daratumumab junto con VRd alcanzaron la negatividad de la enfermedad mínima residual (EMR), es decir, no se detectaron células cancerosas con las pruebas más sensibles disponibles. Esta cifra contrastó con el 39,4% del grupo que recibió solo el tratamiento con VRd.
Además, el 48,7% de los pacientes tratados con la combinación que incluía daratumumab logró una EMR negativa sostenida durante al menos 1 año, comparado con el 26,3% del grupo control. También se observaron tasas superiores de respuesta completa (81,2% frente a 61,6%) y una reducción del 43% en el riesgo de progresión o muerte. Asimismo, se registró una mayor sobrevida libre de progresión, lo que significa que los pacientes vivieron más tiempo sin que la enfermedad avanzara.
“Este avance representa un cambio significativo en nuestra estrategia terapéutica para pacientes con mieloma múltiple que no son elegibles para recibir un trasplante autólogo de médula ósea”, explicó la Dra. Paola Ochoa, hematóloga, médica de planta del Servicio de Hematología y Trasplante Hematopoyético del Instituto Alexander Fleming.
Asimismo, la especialista añadió: “La profundidad de la respuesta lograda, en especial alcanzar y mantener la negatividad de la enfermedad mínima residual, es un factor crucial que podría traducirse en una sobrevida prolongada”.
“La posibilidad de contar con un tratamiento eficaz y bien tolerado desde las etapas iniciales de la enfermedad permite modificar el curso clínico del mieloma múltiple, y lo más relevante es que esto se logra sin exponer al paciente a terapias agresivas, lo cual es fundamental en personas mayores o con enfermedades crónicas concomitantes”vgcxMA , agregó la Dra. María Victoria Mateos, hematóloga y consultora del Departamento de Hematología y Profesora Titular de Medicina en la Universidad de Salamanca, España.
“Con esta aprobación, reafirmamos nuestro compromiso con la innovación y con mejorar el acceso a terapias transformadoras para los pacientes. El mieloma múltiple sigue siendo una enfermedad desafiante, pero con las actuales opciones terapéuticas disponibles, como daratumumab, estamos convencidos de estar cada vez más cerca de transformar el curso de la enfermedad”, destacó el Dr. Ariel Perelsztein, Director de Asuntos Médicos y Regulatorios de Johnson & Johnson Latinoamérica Sur.
En Argentina, la incorporación de esta nueva indicación permite desafiar el curso de la enfermedad en pacientes con hasta el momento opciones terapéuticas limitadas y que puedan acceder a un tratamiento que ofrece mejores perspectivas de control de la enfermedad, con un perfil de seguridad predecible.
Fuente: Noticias Argentinas
